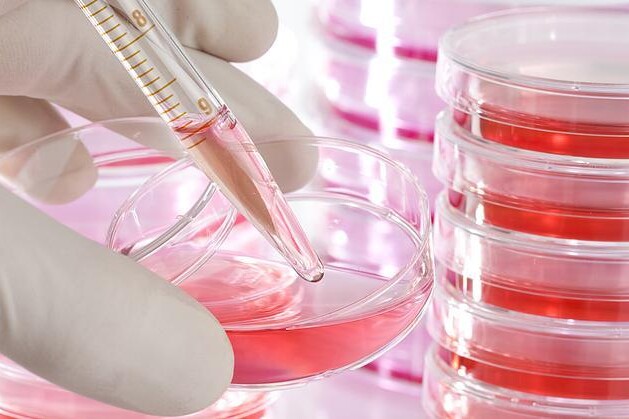
Rakovina prostaty

Dehydratace je nedostatek tekutin v těle. Ohrožuje především děti a staré lidi.

Rakovina prostaty je velice závažné onemocnění, jehož výskyt se neustále zvyšuje. Jde o druhý nejčastější nádor, který se vyskytuje u mužů. Důležitá je opět prevence, tedy každý rok navštěvovat urologa. Pokud se objeví poruchy močení, vyhledejte co nejdříve lékaře, zpravidla to bude zvětšená prostata, ale jelikož symptomy jsou zde podobné, nepodceňujte je. Čím dříve se onemocnění zachytí, tím lepší je prognóza.
Prostata neboli předstojná žláza je orgán uložený pod močovým měchýřem, jehož centrem prochází močová trubice. Za prostatou je uložen konečník, kterým lze tuto žlázu dobře vyšetřit, tomuto vyšetření se říká per rectum. Hlavní funkcí je produkce prostatického sekretu, který je součástí ejakulátu, usnadňuje pohyb spermií a zajišťuje jejich delší přežívání. Rakovina prostaty je velice závažné onemocnění, jehož výskyt se stále zvyšuje. Díky dřívějšímu záchytu a následné léčbě se ale počet úmrtí nenavyšuje. Jde o druhý nejčastější nádor, který se vyskytuje u mužů.
Příčiny rozvoje rakoviny nejsou přesně známy. Mezi prokázané rizikové faktory rakoviny prostaty řadíme věk, etnickou příslušnost (u černochů je výskyt dvakrát vyšší) a rodinnou anamnézu, tedy výskyt tohoto nádoru v rodině. Růst nádoru je většinou podporován vyšší hladinou pohlavních hormonů ze skupiny androgenů. Mezi nejasné rizikové faktory rakoviny prostaty patří nepřiměřená strava, fyzická aktivita, dále sexuálně přenosné choroby a obezita.
Onemocnění se vyvíjí plíživě, nejsou přítomny žádné příznaky, není proto výjimečné, že se projeví až vzdálenou metastázou. Známkou pokročilé rakoviny prostaty jsou problémy při močení, se kterými se můžeme setkat také při nenádorovém zvětšení prostaty. Jde hlavně o časté močení (především v noci), problém se započetím močení, nízký proud moči či po vymočení pocit nedostatečného vyprázdnění močového měchýře. Pro nádor svědčí přítomnost krve v moči, ať již zjistitelná laboratorně nebo je viditelná pouhým okem. Také se může objevit krvavé sperma. Celkové příznaky při rakovině prostaty, mezi které patří nechutenství, hubnutí, únava, chudokrevnost, jsou až v pozdním stádiu onemocnění. Jelikož tento nádor často metastazuje do kostí, setkáváme se s bolestmi kostí, hlavně v oblasti páteře. Může dojít až ke zlomeninám, opět nejčastěji ke zlomeninám obratlů.
Nejdůležitější je zachytit rakovinu prostaty co možná nejdříve. Proto je zavedeno preventivní vyšetření prostaty u mužů od 50 let (pokud se nádor prostaty vyskytl v rodině, pak již od 40 let). Přes konečník je vyšetřena prostata pohmatem a dále je odebrána krev, ve které se stanovuje tzv. PSA (prostatický specifický antigen). Pokud odborník pojme podezření, vyšetřuje se prostata ještě ultrazvukem, opět přes konečník. Léčba rakoviny prostaty je volena podle stádia, ve kterém je onemocnění zachyceno. Pokud jde o náhodný nález malého ložiska, může být zvolena méně radikální operační cesta, kdy dochází k vyříznutí nádoru přes močovou trubici. Jsou pak samozřejmě nutné časté prohlídky a bedlivé sledování.
Pokud je nádor omezený na žlázu, odstraňuje se celá prostata nebo je zvolena radioterapie. Při větším rozsahu rakoviny prostaty, kdy už jsou postiženy mízní uzliny nebo jsou objeveny vzdálené metastázy, se volí radioterapie nebo prostatektomie (chirurgické odstranění prostaty) či antihormonální léčba, metody se s výhodou kombinují. Vyskytují-li se bolesti, lze provést záření na kostní ložiska, která jsou velmi účinná a uleví od bolesti.
Prognóza rakoviny prostaty je dána rozsahem onemocnění v době záchytu a také agresivitou nádoru. V prevenci se mohou uplatnit obecné ochranné faktory jako zvýšený příjem zeleniny a ovoce, dále snížený příjem alkoholu a významné je též nekouřit. Důležité je ale především pravidelně navštěvovat každý rok urologa a podstupovat preventivní prohlídku. Pokud se objeví poruchy močení, vyhledejte co nejdříve lékaře, zpravidla to bude zvětšená prostata, ale jelikož symptomy jsou podobné jako u rakoviny prostaty, nepodceňujte je. Čím dříve se onemocnění zachytí, tím je lepší prognóza.
Diskuze